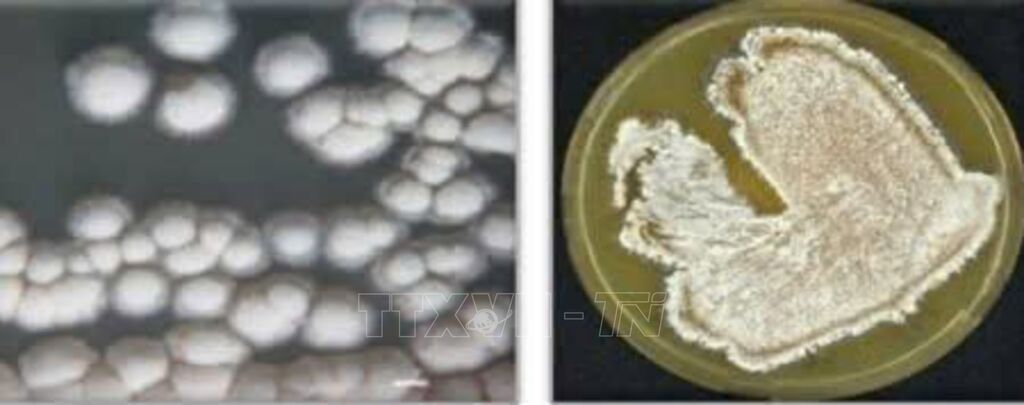

Những đóng góp của các nhà khoa học nữ đã góp phần tạo nền tảng lý luận, thực tiễn phục vụ hoạch định chính sách, nâng cao đời sống con người và hướng tới phát triển bền vững của đất nước.
Trong quá trình phát triển của đất nước, phụ nữ Việt Nam đang ngày càng khẳng định vai trò quan trọng trong đời sống khoa học, với những đóng góp bền bỉ ở nhiều lĩnh vực, từ những ngành nghiên cứu về con người và xã hội, đến các lĩnh vực tự nhiên, kỹ thuật và công nghệ... Những đóng góp của các nhà khoa học nữ đã góp phần tạo nền tảng lý luận, thực tiễn phục vụ hoạch định chính sách, nâng cao đời sống con người và hướng tới phát triển bền vững của đất nước.
Câu chuyện của Phó Giáo sư, Tiến sĩ Nguyễn Thị Phương Châm (Viện trưởng Viện Nghiên cứu Văn hóa, Viện Hàn lâm Khoa học xã hội Việt Nam) và Phó Giáo sư, Tiến sĩ Trần Thị Phương Thảo (Viện Hóa học, Viện Hàn lâm Khoa học và Công nghệ Việt Nam) là minh chứng sinh động cho bản lĩnh, trí tuệ và khát vọng cống hiến của phụ nữ Việt Nam thời đại mới.
* Phụ nữ không cần ưu tiên, mà cần công bằng
Phó Giáo sư, Tiến sĩ Nguyễn Thị Phương Châm, Viện trưởng Viện Nghiên cứu Văn hóa (Viện Hàn lâm Khoa học xã hội Việt Nam) cho rằng, phụ nữ Việt Nam hiện nay đang phải đối mặt với nhiều áp lực trong hành trình phát triển và khẳng định vị thế. Việc cân bằng giữa công việc, gia đình và trách nhiệm xã hội là một thử thách lớn, đặc biệt với những người làm việc trong môi trường nghiên cứu, nơi đòi hỏi năng lực chuyên môn cao, tinh thần trách nhiệm và sự nỗ lực không ngừng. Để phụ nữ có thể phát huy hết khả năng của mình, rất cần sự đồng hành và sẻ chia từ lãnh đạo cơ quan, đồng nghiệp và gia đình, đây chính là điểm tựa giúp họ yên tâm công tác, gắn bó với nghề và đóng góp hiệu quả cho tập thể. Một môi trường làm việc công bằng, thân thiện và tôn trọng sẽ tạo điều kiện để phụ nữ phát huy năng lực, sáng tạo, mang lại giá trị thiết thực cho xã hội.
Trong nhiều năm công tác, Phó Giáo sư Nguyễn Thị Phương Châm là một trong những nhà khoa học tiêu biểu trong lĩnh vực nghiên cứu văn hóa ở Việt Nam. Bà đã chủ trì và tham gia hàng chục đề tài cấp Bộ, cấp Nhà nước, trong đó có các công trình nổi bật như “Xây dựng hệ giá trị văn hóa gắn với gìn giữ, phát triển hệ giá trị gia đình Việt Nam trong thời kỳ mới” và “Tái cấu trúc văn hóa của cư dân vùng biên trong bối cảnh phát triển thương mại Việt Nam - Trung Quốc”. Các nghiên cứu này góp phần cung cấp luận cứ khoa học quan trọng cho việc hoạch định chính sách văn hóa, phát triển nguồn nhân lực và bảo tồn bản sắc dân tộc trong bối cảnh hội nhập.
Với vai trò là Viện trưởng Viện Nghiên cứu Văn hóa, Phó Giáo sư Nguyễn Thị Phương Châm định hướng trọng tâm nghiên cứu của Viện vào các lĩnh vực biến đổi văn hóa, di sản văn hóa phi vật thể và văn hóa cộng đồng, đồng thời chịu trách nhiệm quản lý cổng thông tin và hoạt động học thuật của Viện. Bà đã có những đóng góp quan trọng trong tham vấn chính sách nêu quan điểm chuyên gia trong quá trình xây dựng Dự thảo Luật Di sản văn hóa (sửa đổi) và nhiều diễn đàn chính sách văn hóa, góp phần đưa bằng chứng học thuật vào quá trình hoạch định và thực thi chính sách.
Trên bình diện học thuật quốc tế, Phó Giáo sư Nguyễn Thị Phương Châm nhiều lần hợp tác với Harvard-Yenching Institute (HYI) với tư cách diễn giả và học giả mời, đồng thời đồng biên tập các ấn phẩm nằm trong chuỗi sách học thuật do HYI hỗ trợ, góp phần quảng bá tri thức về văn hóa Việt Nam ra thế giới. Song song với đó, bà còn tham gia đào tạo sau đại học và tổ chức chương trình Văn hóa học tại Học viện Khoa học xã hội, góp phần phát triển đội ngũ nhân lực nghiên cứu văn hóa chất lượng cao cho đất nước.
Trong sự nghiệp nghiên cứu, Phó Giáo sư Nguyễn Thị Phương Châm đã xuất bản hơn 10 chuyên khảo và trên 60 bài báo khoa học trong và ngoài nước về văn hóa làng, văn hóa cộng đồng người Việt ở nước ngoài, văn hóa đô thị và biến đổi xã hội đương đại. Các công trình như “Làng ven đô và sự biến đổi văn hóa”, “Văn hóa cộng đồng Kinh tộc ở Kinh Đảo (Đông Hưng, Quảng Tây, Trung Quốc)” hay nghiên cứu về “vỉa hè Hà Nội không gian công cộng đa chiều” đều được đánh giá cao bởi cách tiếp cận mới, kết hợp giữa lý luận hàn lâm và thực tiễn đời sống. Ngoài hoạt động nghiên cứu, bà còn tham gia đào tạo, hướng dẫn nghiên cứu sinh và tư vấn chính sách, lan tỏa tri thức văn hóa học vào đời sống xã hội...
Theo Phó Giáo sư Nguyễn Thị Phương Châm, phụ nữ không cần được ưu tiên, mà cần được nhìn nhận công bằng, ghi nhận đúng năng lực và những đóng góp thực chất của mình. Chính sự công bằng trong cơ hội và đánh giá giúp phụ nữ tự tin phát triển, khẳng định bản thân và tiếp nối phẩm chất truyền thống “Anh hùng, Bất khuất, Trung hậu, Đảm đang” trong thời kỳ mới.
* Khi đam mê trở thành động lực
Giữa phòng thí nghiệm sáng đèn, hình ảnh người phụ nữ miệt mài bên ống nghiệm, cẩn trọng với từng phản ứng và phép đo, đã trở thành biểu tượng cho tinh thần cống hiến của phụ nữ Việt Nam trong nghiên cứu khoa học. Một trong những gương mặt tiêu biểu ấy chính là Phó Giáo sư, Tiến sĩ Trần Thị Phương Thảo, Trưởng phòng Tổng hợp Hữu cơ, Viện Hóa học (Viện Hàn lâm Khoa học và Công nghệ Việt Nam), người đã dành hơn hai thập kỷ gắn bó với nghiên cứu các hợp chất thiên nhiên, hướng tới những ứng dụng phục vụ sức khỏe con người và phát triển bền vững.
Phó Giáo sư Trần Thị Phương Thảo đã chủ trì và tham gia nhiều đề tài khoa học cấp Bộ, cấp Nhà nước, công bố hơn 90 bài báo trên các tạp chí khoa học uy tín trong và ngoài nước. Hướng nghiên cứu tập trung vào khai thác các hợp chất tự nhiên có hoạt tính sinh học, phục vụ điều trị bệnh truyền nhiễm, đây là lĩnh vực mang ý nghĩa xã hội sâu sắc trong bối cảnh thế giới liên tục đối mặt với dịch bệnh và biến đổi khí hậu. Trong đó, hướng nghiên cứu phát triển các hoạt chất từ dược liệu Việt Nam để hỗ trợ điều trị bệnh sốt xuất huyết là một trong những hướng đi tiêu biểu, thể hiện tinh thần khoa học gắn với thực tiễn đời sống và lợi ích cộng đồng.
Theo đuổi ngành Hóa hữu cơ từ khi còn là sinh viên Trường Đại học Khoa học Tự nhiên (Đại học Quốc gia Hà Nội), Phó Giáo sư Trần Thị Phương Thảo sớm xác định nghiên cứu khoa học là con đường dài, đòi hỏi sự kiên định và say mê. Sau khi bảo vệ thành công luận án Tiến sĩ tại Trường Đại học Martin-Luther Halle-Wittenberg (Cộng hòa Liên bang Đức) năm 2006, bà trở về nước, tiếp tục đẩy mạnh hướng nghiên cứu tổng hợp và biến đổi cấu trúc hợp chất hữu cơ, đặc biệt là các dẫn xuất tự nhiên có hoạt tính sinh học.
Trong giai đoạn 2019-2023, Phó Giáo sư Trần Thị Phương Thảo là chủ nhiệm đề tài “Nghiên cứu sàng lọc chất ức chế ClpC1 có tiềm năng kháng lao từ xạ khuẩn phân lập ở Việt Nam”. Đây là hướng tiếp cận mới nhằm tìm kiếm hợp chất có khả năng chống lại vi khuẩn lao, đặc biệt là các chủng kháng đa thuốc, một trong những thách thức lớn của y học hiện đại. Kết quả nghiên cứu mở ra triển vọng ứng dụng các hợp chất thiên nhiên trong phát triển thuốc điều trị bệnh lao hiệu quả, an toàn, thể hiện năng lực và tinh thần trách nhiệm của các nhà khoa học Việt Nam trước những vấn đề y tế toàn cầu.
Không chỉ thành công trong nghiên cứu, Phó Giáo sư Trần Thị Phương Thảo còn là đồng tác giả của bốn bằng độc quyền sáng chế và giải pháp hữu ích, trong đó có hai sáng chế quốc tế. Một trong những công trình tiêu biểu là sáng chế "Esterelongationsverfahren zum sequenzgesteuerten Aufbau alternierender Peptid-Peptoid-Polymere”, được đăng ký tại Cộng hòa Liên bang Đức, mở ra phương pháp tổng hợp mới các peptid-peptoid trên nền polymer. Công trình này có tiềm năng ứng dụng trong y học hiện đại, đặc biệt trong điều trị các bệnh lý phức tạp như ung thư, thể hiện năng lực sáng tạo và tầm nhìn hội nhập của các nhà khoa học Việt Nam.
Song song với nghiên cứu, Phó Giáo sư Trần Thị Phương Thảo còn tâm huyết với công tác đào tạo, hướng dẫn thành công cho năm nghiên cứu sinh và sáu học viên cao học, luôn đề cao tinh thần tự học, tư duy phản biện và sáng tạo trong nghiên cứu. Với phong cách làm việc nghiêm túc, cởi mở và khích lệ, Phó Giáo sư Trần Thị Phương Thảo truyền cảm hứng cho nhiều sinh viên theo đuổi con đường khoa học bằng niềm tin và tinh thần phụng sự xã hội.
Như nhiều nhà khoa học nữ khác, Phó Giáo sư Trần Thị Phương Thảo cũng phải đối mặt với áp lực trong việc cân bằng giữa công việc và cuộc sống gia đình. Những chuyến công tác dài ngày, những đêm làm việc trong phòng thí nghiệm đòi hỏi nhiều hy sinh, nhưng sự cảm thông và chia sẻ từ người thân, đặc biệt từ cha mẹ đã trở thành nguồn động viên lớn. "Từ họ, tôi học được tinh thần kiên trì, trách nhiệm và tình yêu tri thức, những giá trị giúp tôi bền bỉ theo đuổi sự nghiệp nghiên cứu", Phó Giáo sư Trần Thị Phương Thảo chia sẻ.
Hiện nay, Phó Giáo sư Trần Thị Phương Thảo cùng nhóm nghiên cứu tiếp tục đẩy mạnh các hướng nghiên cứu ứng dụng cao, tập trung khai thác nguồn hợp chất tự nhiên từ thực vật Việt Nam để tìm kiếm hoạt chất kháng virus Dengue gây bệnh sốt xuất huyết, vấn đề y tế công cộng cấp thiết khi thế giới chưa có thuốc điều trị đặc hiệu. Những nỗ lực ấy không chỉ góp phần phát triển khoa học Việt Nam theo hướng ứng dụng, mà còn khẳng định vai trò và trách nhiệm của phụ nữ trong hành trình xây dựng tương lai bền vững cho đất nước.
Có thể thấy, những tấm gương của các nhà khoa học nữ như Phó Giáo sư, Tiến sĩ Nguyễn Thị Phương Châm và Phó Giáo sư, Tiến sĩ Trần Thị Phương Thảo chỉ là hai trong hàng nghìn tấm gương phụ nữ Việt Nam đang miệt mài cống hiến trên mọi lĩnh vực. Trong giai đoạn hội nhập và phát triển như hiện nay, những đóng góp của các nhà khoa học nữ Việt Nam càng trở nên có ý nghĩa đối với sự phát triển bền vững của đất nước./.